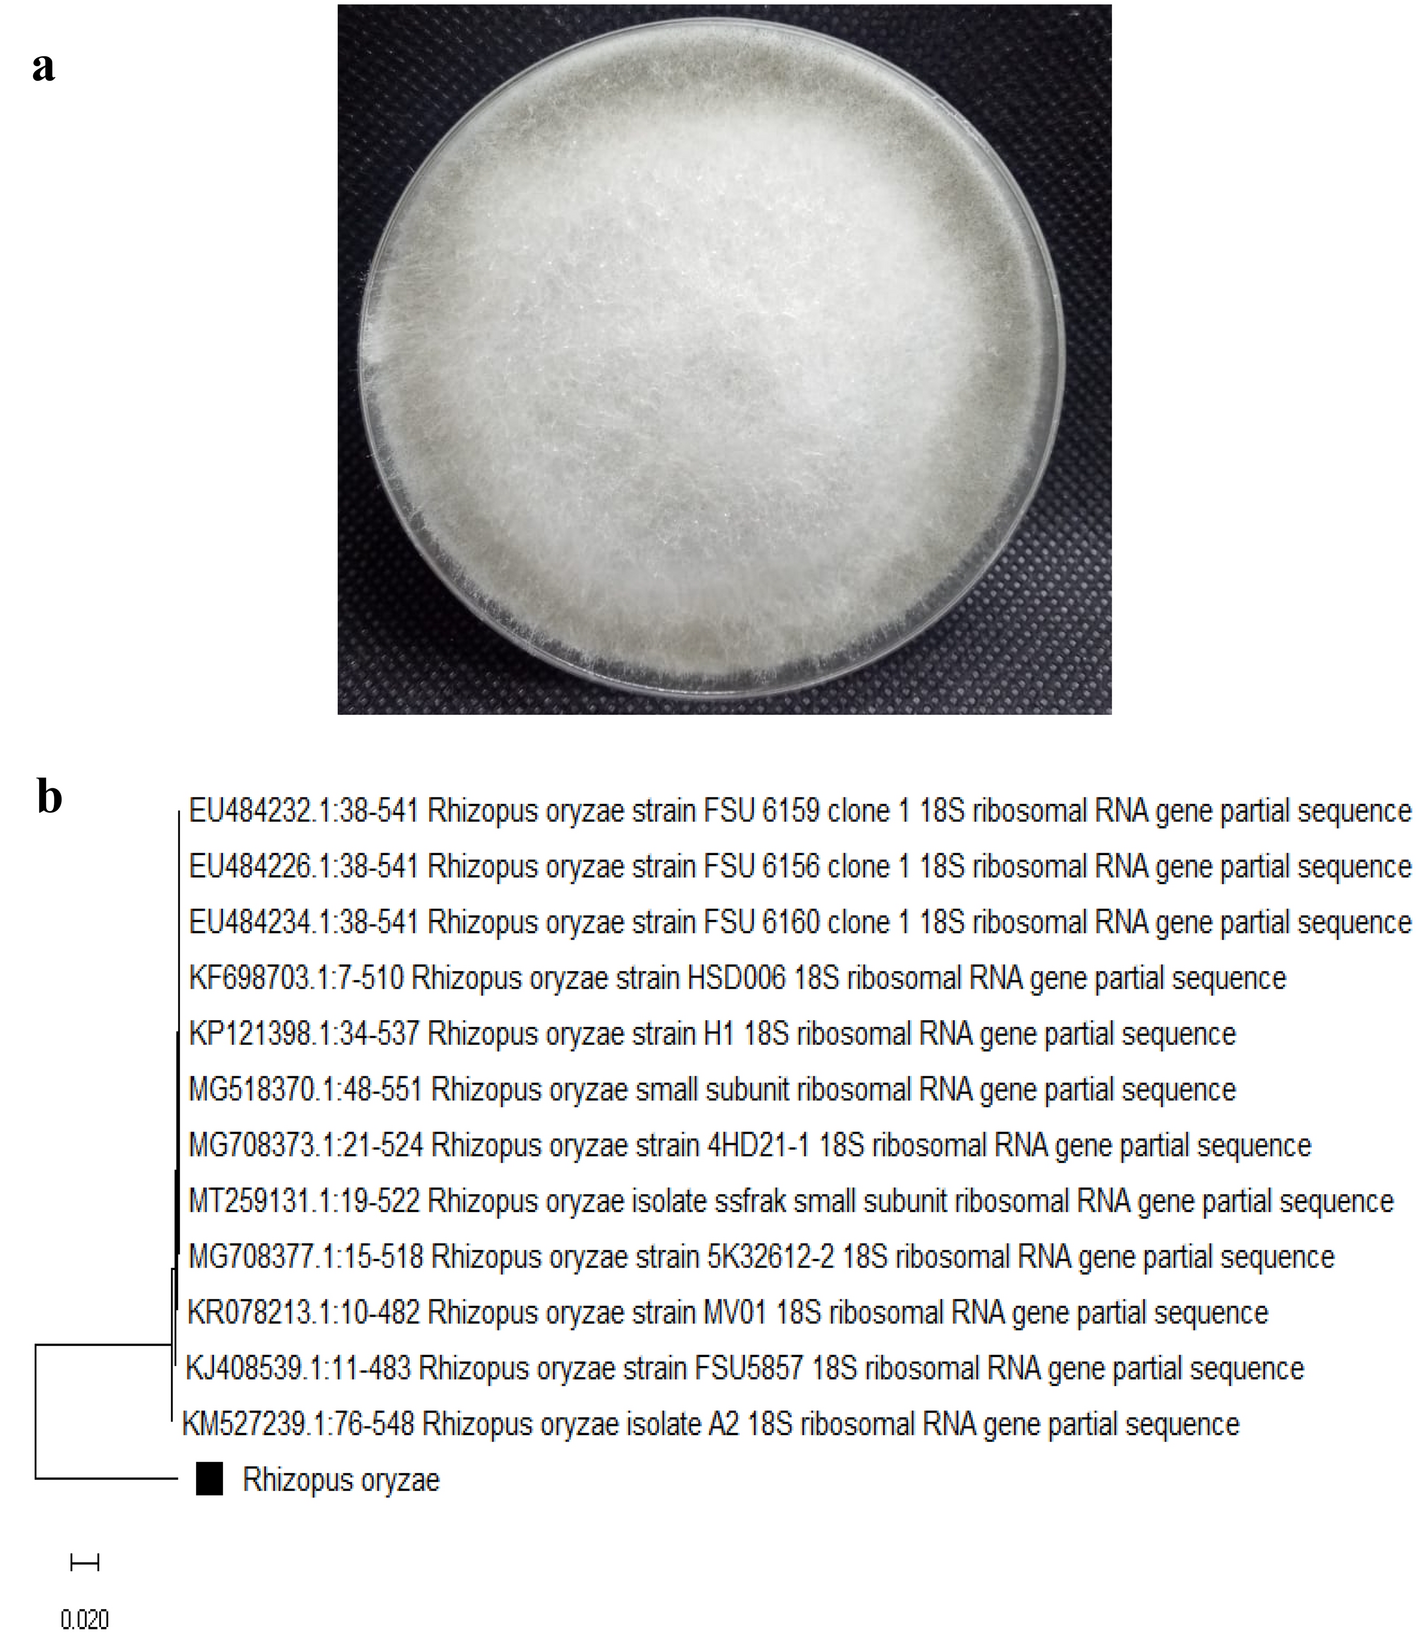
Figure 1

Figure 1

Plate of the pure isolate growth morphology (a) as well as the identification tree of molecular identification (b). Rhizopus oryzae.
Plate of the pure isolate growth morphology (a) as well as the identification tree of molecular identification (b). Rhizopus oryzae.